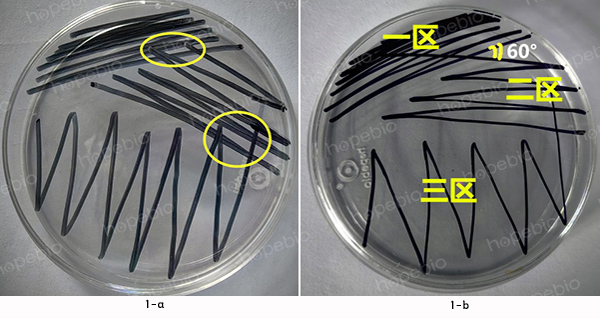
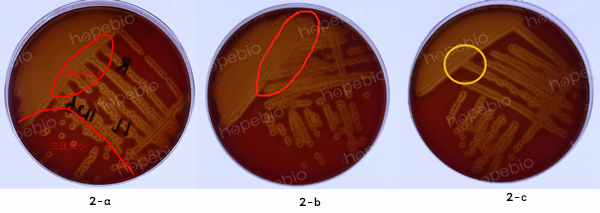
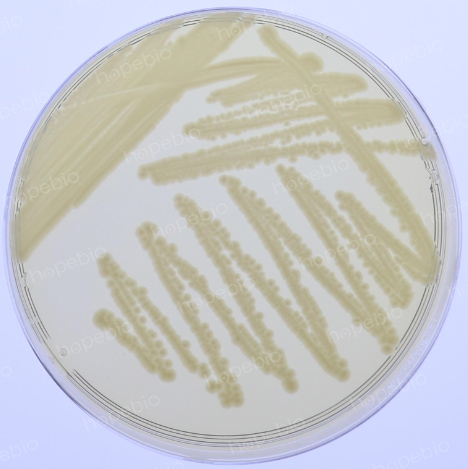
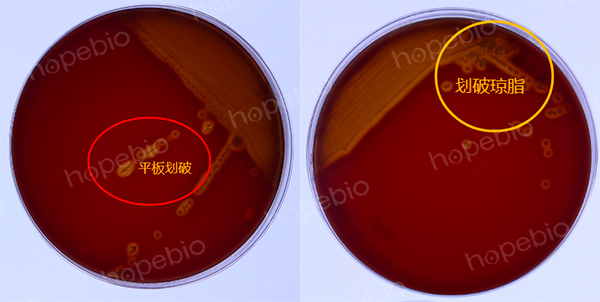
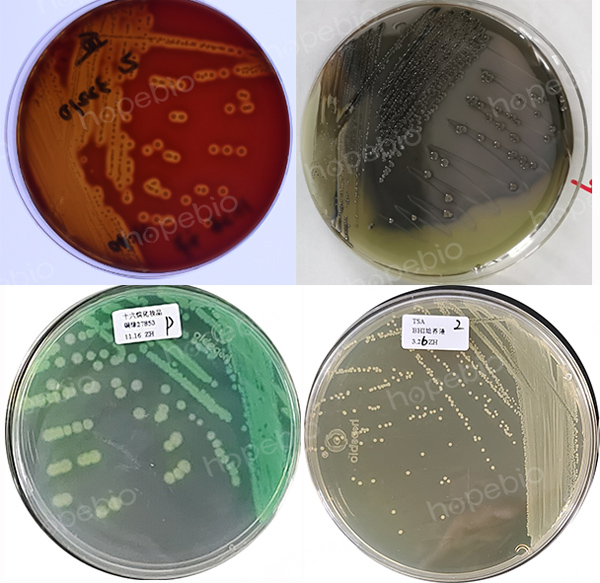

海博微信公众号
海博微信公众号
 海博天猫旗舰店
海博天猫旗舰店


 海博微信公众号
海博微信公众号
 海博天猫旗舰店
海博天猫旗舰店




一、简介
在微生物研究中,划线分离是常见操作,其目的在于将单一的微生物菌株从混合群体中分离出来,或者将细菌在琼脂平板表面充分地分散开,使单个细菌能固定在一点上繁殖,形成单个菌落,以达到分离纯化的目的。
划线分离具体又有很多方式:三区划线法、四区划线法、十六线法、“之”字划线法等。其中“三区划线法”是实验室最常用的平板划线接种方法。具体操作如下:将平板分为3个区域,并分别标记为1、2、3区。首先在1区进行划线操作,起始位置可反复划线,然后“之”字形划线,划线区域不超过平板1/3;然后平板旋转60度,从1区的划线末端引出1-2条线继续在2区之字形划线,之后连续划线不再与1区接触,以此类推,进行3区的划线(如图1-a),总体来说,1区和2区总共约占整个平板面积的一半,另一半全部作为第3区域,一定要注意,务必保证当前操作的划线只能与相邻前一区域相交,绝不能与其他区域的划线有重叠。通过这种方法,能大大提高在2区或3区得到单一微生物菌株的概率。或者从1区往2区引线时,只引一条线,使这条线尽量与1区的所有线都有接触(如图1-b)
图1 三区划线的两种引线方式
二、异常情况
理论上看起来很简单,但在实际操作中,经常会遇到各种问题。最终导致的结果就是划不出单菌落或者单菌落很少。为什么划不出单菌落?常见原因如下:
1、菌落生长过密
造成菌落生长过密的原因主要有以下几个方面:没有充分利于好划线区域(如图2-a);各区域线过于密集,线与线之间重叠(如图2-b);与前一区交叉过多(如图2-a,2-c);或者划线时接种环接触点变动,未始终保持接种环的一点接触琼脂表面,造成3区沾附的菌太多。
图2 菌落生长太密,划不出单菌落的情形
为避免菌落过密造成划不出单菌落的问题,可以采取以下几种方法:待接种的细菌菌量过多时,第1区划线后务必灼烧接种环,再进行2区划线,2区与3区之间是否需要烧环,根据试验经验而定。通常来说,如果使用菌液进行划线,2区和3区是不需要烧环的,但如果使用菌苔划线,因为接种环上沾附的菌体很多,只要不是太难生长的菌,划线时必须烧环,否则很容易长得太密,分离不出单菌落(如图3)。
图3 挑取菌苔划线平板时,烧环不彻底划出的平板
2、菌落生长过少
造成菌落生长太少,无法长出足够多单菌落的原因主要有以下三点:
(1)本身菌种生长比较差,不容易培养。
(2)本来蘸取的菌液比较少,又多次烧环造成单菌落很少,这种情况通常出现在使用菌液进行划线,每个区都烧环时。
(3)在平板划线过程中,烧过的接种环未充分凉透,接种环过热会导致细菌死亡,即虽然接种环沾到了菌体,但是多数都烫死了,从而无法在平板上生长繁殖。因此在划线过程中,需要控制接种环的温度,避免过热。
(4)未掌握好划线力度与角度,划破琼脂,接种环上沾附的菌体大部分沾附到了划破的琼脂中,在后面的划线过程中,环上沾附的菌体很少,甚至接种环与培养基接触的部位根本不再有菌,自然划不出单菌落(如图4)。
图4 因划破琼脂平板造成单菌落太少的情况
三、好的划线效果展示
比较理想的三区划线平板上,菌体生长的状态应该是:第1区和第2区前部的细菌生长成“直线”,第2区后部的细菌生长呈“虚线”,第三区呈“虚线”和离散的“小点”(即单菌落)。
本文特挑选几个划线效果较好的平板进行展示(如图5),提供参考。
图5 分离效果较好的划线平板
四、注意事项
采用分区划线法进行微生物的接种,为了达到较好的分离效果,要格外注意以下几点:
1. 接种环的灭菌:在进行平板划线前,需要将接种环在火焰上灼烧至烧红,待其冷却后再进行接种操作。不烧环,通常会造成菌量太多,太密,长不成单菌落,如果接种环灼烧后未冷却就进行划线,可能会因为温度过高杀死菌种,造成下一区接种的菌量太少而无单菌落生长。
2. 划线技巧:划线时要注意角度,保持接种环的一个面始终与平板接触,中间不能换面;要保证划线不间断,但又不与划过的路线重复或重叠。
3. 防止污染:在进行划线操作时,要注意避免外界污染。例如,在打开试管塞、接种环挑取菌液等操作时,要在火焰旁进行。
更加直观的划线手法,可参考视频:菌株的分离和纯化。
总之,平板划线法虽然非常简单,但仍有很多细节需要注意,主要考虑使用的菌种是常规菌还是不易成活的菌,是使用的菌苔还是菌液,具体操作还包括接种环的灭菌、划线技巧、防止污染、操作规范等方面。在理论基础上进行反复练习,三分学七分练才是正道,一定不要十分学,一点都不练,这样即使学得再好,也划不出漂亮的三区。如果没有理论指导和规范的样板,盲目练习,一样得不出满意的结果。只要在理论指导下反复练习,每个人都能成为划线高手。
注:本文属海博生物原创,未经允许不得转载。
上一篇:常见问题答疑(细菌的接种)
| 相关文章: | |



